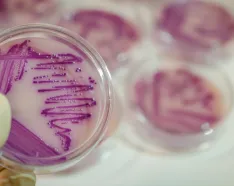
Image for post: Health Alert: Local E. coli Case Linked to Romaine Lettuce Warnings

Authors

Rudolf Kotula, MD
Dr. Rudolf Kotula is a board-certified infectious disease physician. He specializes in areas such as antibiotic resistance, travel medicine and infection prevention.
You can visit Dr. Kotula at Methodist Physicians Clinic.